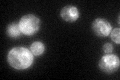

View description
1-acyl-sn-glycerol-3-phosphate acyltransferase, catalyzes the acylation of lysophosphatidic acid to form phosphatidic acid, a key intermediate in lipid metabolism; enzymatic activity detected in lipid particles and microsomes
Localization:
Intensity:
Fold change:
Significance:
-
C’ GFP library in SD

ER82.31 -
N' NOP1pr-GFP in SD

ER87.7507 -
N' TEF2pr-mCherry in SD

ER115.356 -
N' NATIVEpr-GFP in SD

ER52.6416 -
N' TEF2pr-VC and Cyto-VN in SD

below threshold31.0847 -
C’ GFP library in SD+DTT

ER92.641.12No -
C’ GFP library in SD+H2O2
vacuoleN/AN/ANo -
C’ GFP library in Starvation Media

vacuoleN/AN/AYes -
C’ GFP library on the background of Pup2-DaMP

ER -
C’ GFP library on the background of CCT mutant

ER67.62950.821581No
